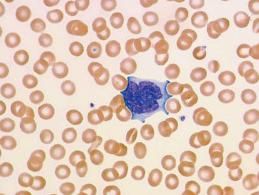
傳染性單核細胞增多

編輯本段概述
傳染性單核細胞增多症是由EB病毒所致的急性自限性傳染病。其臨床特徵為發熱,咽喉炎,淋巴結腫大,外周血淋巴細胞顯著增多並出現異常淋巴細胞,嗜異性凝集試驗陽性,感染後體內出現抗EBV抗體。病因
(一)傳染:帶毒者及病人為本病的傳染源。(二)傳播途徑:80%以上患者鼻咽部有EB病毒存在,經口鼻密切接觸為主要傳播途徑,也可經飛沫及輸血傳播。
(三)易感人群:人群普遍易感,
症狀
潛伏期5~15天,一般為9~11天。起病急緩不一。約40%患者有前驅症狀,歷時4~5天,如乏力、頭痛、納差、噁心、稀便、畏寒等,本病的症狀雖多樣化,但大多數可出現較典型的症狀。(一)發熱:高低不一,多在38~40℃之間。熱型不定。熱程自數日至數周,甚至數月。可伴有寒戰和多汗。中毒症狀多不嚴重。
(二)淋巴結腫大:見於70%的患者。以頸淋巴結腫大最為常見,腋下及腹股溝部次之。
(三)咽痛:雖僅有半數患者主訴咽痛,但大多數病例可見咽部充血,少數患者咽部有潰瘍及偽膜形成,可見出血點。齒齦也可腫脹或有潰瘍。喉和氣管的水腫和阻塞少見。
(四)肝脾腫大。
(五)皮疹。
(六)神經系統症狀。
檢查
1.血象:白細胞總數正常或稍增多,最高可達30~50×109/L。2.嗜異性凝集試驗:該試驗在病程早期即呈陽性,約為40%。
3.EBV抗體檢測。
治療
本病無特異性治療,以對症治療為主,患者大多能自愈。當並發細菌感染時,如咽部、扁桃體的β-溶血性鏈球菌感染可選用青黴G、紅黴素等抗生素,有人認為使用甲硝唑(滅滴靈)或氯林可黴素也有一定效果。腎上腺皮質激素可用於重症患者,如咽部、喉頭有嚴重水腫,出現神經系統併發症、血小板減少性紫癜、心肌炎、心包炎等,可改善症狀,消除炎症。但一般病例不宜採用。